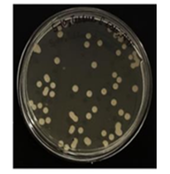
Human infected tissue treated

8537 Greenbriar St. || Wichita KS || 67226 || 316-796 4110
MSI Automation

Magnetic Hyperthermia: Infection Treatment
Antibiotics is increasingly ineffective against infections. (WHO) Hospitals report 30-50% of infections are now Drug-Resistant. Magnetic Hyperthermia can be used to safely treat Diabetic Infection as; (1) Foot Ulcers (DFU), (2) Lower Limb Infections, and (3) Bone Infections. Magnetic Hyperthermia can be combined with Antibiotics to deliver more successful treatment results than using Antibiotics alone.

Magnetic Hyperthermia / Stem Cell Gene Therapy
Magnetic Hyperthermia is used for treating cancerous tumors and for Stem Cell Gene Therapy. This FDA approved RF heating can be focused at a tumor infused with cancer killing nanoparticles. The heating activates the nanoparticles to attack and over-heat the tumor. Magnetic Hyperthermia is also used to guide and activate therapeutic genes within Stem Cells to enhance Cancer Therapy.









